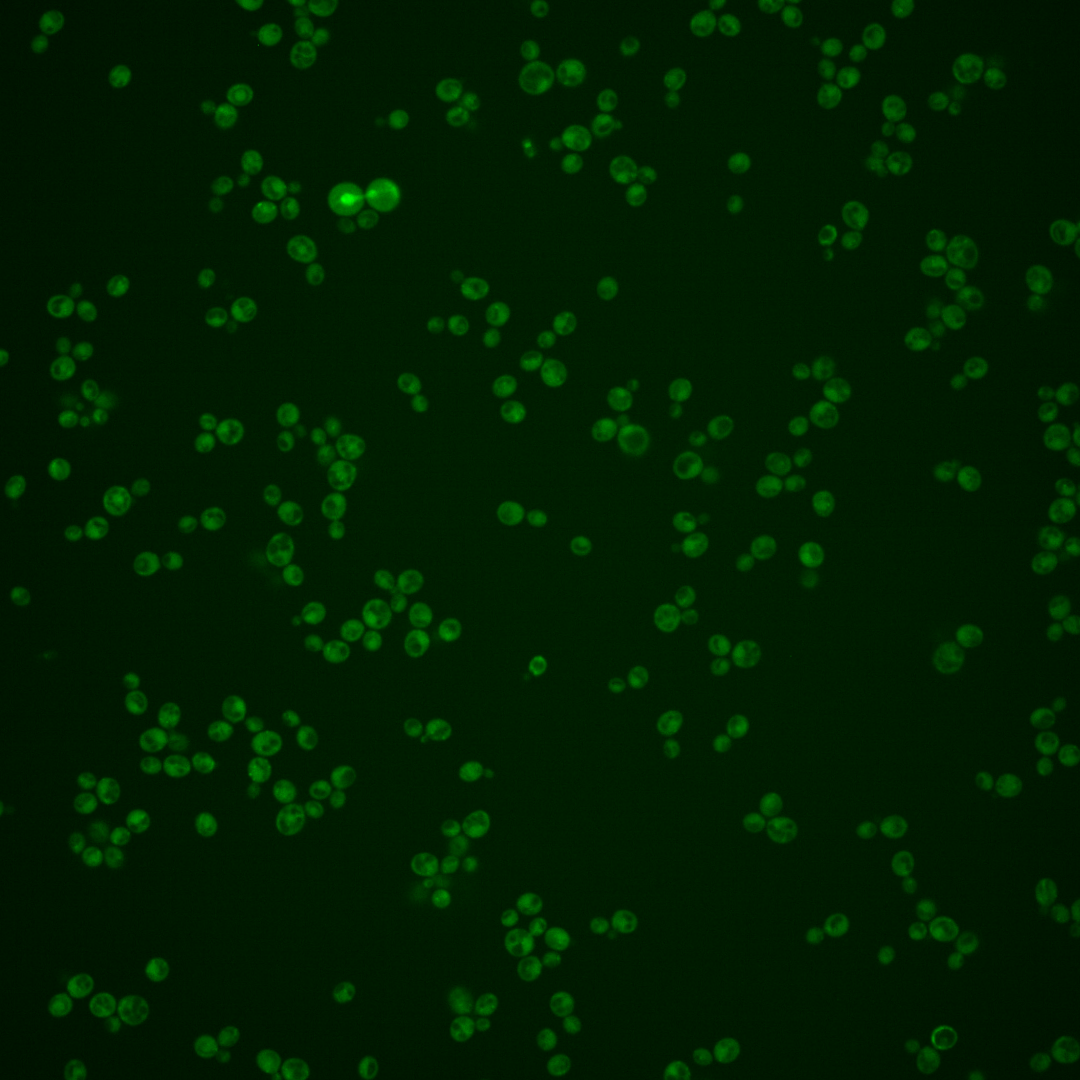

| Standard name | |
|---|---|
| Human Ortholog | |
| Description | 6-phosphofructo-2-kinase; catalyzes synthesis of fructose-2,6-bisphosphate; inhibited by phosphoenolpyruvate and sn-glycerol 3-phosphate, expression induced by glucose and sucrose, transcriptional regulation involves protein kinase A |
Micrographs




















































































Sub-cellular Localization
Yeast GFP Assignment
Protein Abundance
Localization Change
External localization resources
| ensLOC | DeepLoc | |||||||||||||||||||||||
|---|---|---|---|---|---|---|---|---|---|---|---|---|---|---|---|---|---|---|---|---|---|---|---|---|
| Localization | WT1 | WT2 | WT3 | RAP60 | RAP140 | RAP220 | RAP300 | RAP380 | RAP460 | RAP540 | RAP620 | RAP700 | HU80 | HU120 | HU160 | rpd3Δ_1 | rpd3Δ_2 | rpd3Δ_3 | WT1 | WT2 | WT3 | AF100 | AF140 | AF180 |
| Cortical Patches | 1 | 0 | 2 | 1 | 0 | 0 | 1 | 0 | 0 | 1 | 0 | 0 | 3 | 3 | 2 | – | 0 | – | 9 | 1 | 6 | 0 | 3 | 6 |
| Bud | 6 | 1 | 4 | 1 | 2 | 6 | 21 | 10 | 24 | 20 | 18 | 18 | 0 | 0 | 1 | – | 0 | – | 2 | 0 | 1 | 0 | 2 | 5 |
| Bud Neck | 0 | 0 | 0 | 0 | 0 | 0 | 0 | 2 | 0 | 0 | 0 | 0 | 0 | 0 | 2 | – | 0 | – | 1 | 4 | 2 | 1 | 2 | 3 |
| Bud Site | 0 | 0 | 0 | 0 | 0 | 0 | 0 | 2 | 1 | 3 | 1 | 5 | 0 | 0 | 0 | – | 0 | – | – | – | – | – | – | – |
| Cell Periphery | 1 | 0 | 0 | 0 | 2 | 3 | 1 | 1 | 0 | 3 | 2 | 1 | 1 | 3 | 3 | – | 0 | – | 0 | 0 | 0 | 0 | 2 | 0 |
| Cytoplasm | 251 | 61 | 171 | 267 | 360 | 345 | 397 | 374 | 234 | 295 | 152 | 237 | 181 | 284 | 343 | – | 8 | – | 222 | 73 | 144 | 81 | 236 | 265 |
| Endoplasmic Reticulum | 11 | 4 | 5 | 7 | 2 | 3 | 5 | 2 | 0 | 3 | 2 | 1 | 20 | 11 | 11 | – | 1 | – | 8 | 1 | 5 | 0 | 1 | 3 |
| Endosome | 3 | 0 | 17 | 10 | 36 | 17 | 21 | 29 | 3 | 2 | 1 | 1 | 5 | 12 | 28 | – | 2 | – | 26 | 7 | 36 | 9 | 10 | 17 |
| Golgi | 0 | 0 | 0 | 1 | 0 | 0 | 0 | 0 | 1 | 0 | 0 | 0 | 0 | 0 | 1 | – | 0 | – | 0 | 0 | 2 | 0 | 0 | 0 |
| Mitochondria | 26 | 3 | 4 | 13 | 41 | 136 | 393 | 282 | 351 | 418 | 346 | 358 | 0 | 0 | 2 | – | 0 | – | 33 | 11 | 24 | 2 | 9 | 24 |
| Nucleus | 0 | 1 | 0 | 0 | 0 | 2 | 11 | 12 | 13 | 14 | 2 | 13 | 1 | 1 | 0 | – | 0 | – | 0 | 0 | 0 | 2 | 1 | 1 |
| Nuclear Periphery | 5 | 0 | 0 | 0 | 0 | 2 | 10 | 2 | 5 | 0 | 0 | 5 | 0 | 0 | 0 | – | 0 | – | 1 | 0 | 1 | 0 | 1 | 0 |
| Nucleolus | 0 | 0 | 0 | 0 | 0 | 0 | 0 | 0 | 1 | 0 | 0 | 2 | 0 | 0 | 0 | – | 0 | – | 0 | 0 | 0 | 0 | 0 | 0 |
| Peroxisomes | 0 | 0 | 0 | 0 | 0 | 0 | 0 | 0 | 0 | 0 | 0 | 0 | 0 | 0 | 1 | – | 0 | – | 0 | 0 | 0 | 0 | 0 | 0 |
| SpindlePole | 1 | 0 | 1 | 1 | 2 | 0 | 2 | 4 | 5 | 1 | 0 | 0 | 2 | 1 | 4 | – | 1 | – | 12 | 2 | 7 | 1 | 7 | 8 |
| Vac/Vac Membrane | 7 | 0 | 12 | 23 | 22 | 29 | 98 | 125 | 71 | 91 | 59 | 98 | 1 | 8 | 16 | – | 6 | – | 8 | 4 | 3 | 1 | 3 | 6 |
| Unique Cell Count | 292 | 67 | 200 | 307 | 432 | 460 | 746 | 675 | 555 | 647 | 452 | 547 | 208 | 312 | 392 | 16 | 332 | 109 | 245 | 105 | 288 | 351 | ||
| Labelled Cell Count | 312 | 70 | 216 | 324 | 467 | 543 | 960 | 845 | 709 | 851 | 583 | 739 | 214 | 323 | 414 | 18 | 332 | 109 | 245 | 105 | 288 | 351 | ||
Yeast GFP Assignment
Protein Abundance
| Screen | WT1 | WT2 | WT3 | RAP60 | RAP140 | RAP220 | RAP300 | RAP380 | RAP460 | RAP540 | RAP620 | RAP700 | HU80 | HU120 | HU160 | rpd3Δ_1 | rpd3Δ_2 | rpd3Δ_3 | AF100 | AF140 | AF180 |
|---|---|---|---|---|---|---|---|---|---|---|---|---|---|---|---|---|---|---|---|---|---|
| Mean Cell GFP Intensity (1e-4) | 4.1 | 4.7 | 5.3 | 6.3 | 5.4 | 4.6 | 4.3 | 4.4 | 4.0 | 3.9 | 3.7 | 3.7 | 7.3 | 7.1 | 6.4 | – | 8.1 | – | 7.0 | 7.1 | 6.9 |
| Std Deviation (1e-4) | 0.6 | 0.7 | 1.3 | 1.7 | 1.6 | 1.1 | 1.1 | 1.2 | 1.1 | 1.1 | 1.2 | 1.0 | 1.3 | 1.2 | 1.2 | – | 2.0 | – | 1.5 | 1.5 | 1.4 |
| Intensity Change (Log2) | – | – | – | 0.24 | 0.03 | -0.21 | -0.31 | -0.28 | -0.42 | -0.44 | -0.52 | -0.52 | 0.46 | 0.42 | 0.26 | – | 0.61 | – | 0.39 | 0.41 | 0.38 |
Localization Change
| Localization | RAP60 | RAP140 | RAP220 | RAP300 | RAP380 | RAP460 | RAP540 | RAP620 | RAP700 | HU80 | HU120 | HU160 | rpd3Δ_1 | rpd3Δ_2 | rpd3Δ_3 |
|---|---|---|---|---|---|---|---|---|---|---|---|---|---|---|---|
| Actin | – | – | – | – | – | – | – | – | – | – | – | – | – | – | – |
| Bud | – | – | – | – | – | – | – | – | – | – | – | – | – | – | – |
| Bud Neck | – | – | – | – | – | – | – | – | – | – | – | – | – | – | – |
| Bud Site | – | – | – | – | – | – | – | – | – | – | – | – | – | – | – |
| Cell Periphery | – | – | – | – | – | – | – | – | – | – | – | – | – | – | – |
| Cyto | – | – | – | – | – | – | – | – | – | – | – | – | – | – | – |
| Endoplasmic Reticulum | – | – | – | – | – | – | – | – | – | – | – | – | – | – | – |
| Endosome | – | – | – | – | – | – | – | – | – | – | – | – | – | – | – |
| Golgi | – | – | – | – | – | – | – | – | – | – | – | – | – | – | – |
| Mitochondria | – | – | – | – | – | – | – | – | – | – | – | – | – | – | – |
| Nuclear Periphery | – | – | – | – | – | – | – | – | – | – | – | – | – | – | – |
| Nuc | – | – | – | – | – | – | – | – | – | – | – | – | – | – | – |
| Nucleolus | – | – | – | – | – | – | – | – | – | – | – | – | – | – | – |
| Peroxisomes | – | – | – | – | – | – | – | – | – | – | – | – | – | – | – |
| SpindlePole | – | – | – | – | – | – | – | – | – | – | – | – | – | – | – |
| Vac | – | – | – | – | – | – | – | – | – | – | – | – | – | – | – |
| Cortical Patches | – | – | – | – | – | – | – | – | – | – | – | – | – | – | – |
| Cytoplasm | – | – | – | – | – | – | – | – | – | – | – | – | – | – | – |
| Nucleus | – | – | – | – | – | – | – | – | – | – | – | – | – | – | – |
| Vacuole | – | – | – | – | – | – | – | – | – | – | – | – | – | – | – |
External localization resources
Images






























Protein Concentration and Protein Localization Data
| R1 | R2 | R3 | ||||||||||||||||
|---|---|---|---|---|---|---|---|---|---|---|---|---|---|---|---|---|---|---|
| G1 Pre-START | G1 Post-START | S/G2 | Metaphase | Anaphase | Telophase | G1 Pre-START | G1 Post-START | S/G2 | Metaphase | Anaphase | Telophase | G1 Pre-START | G1 Post-START | S/G2 | Metaphase | Anaphase | Telophase | |
| Concentration | 3.3379 | 3.8631 | 3.7046 | 3.4984 | 3.0217 | 3.461 | -0.2972 | 1.0725 | 1.0702 | 1.1865 | 0.2656 | 0.7568 | -0.5437 | 1.0544 | 0.3708 | 0.258 | 0.1714 | 0.002 |
| Actin | 0.0194 | 0.0012 | 0.0224 | 0.0097 | 0.0195 | 0.0027 | 0.0219 | 0.0084 | 0.0028 | 0.0569 | 0.003 | 0.003 | 0.0003 | 0.0005 | 0.001 | 0.0009 | 0.0005 | 0.0005 |
| Bud | 0.0009 | 0.0018 | 0.0009 | 0.0004 | 0.0005 | 0.0003 | 0.0004 | 0.0029 | 0.0006 | 0.0003 | 0.0024 | 0.0101 | 0.0001 | 0.0003 | 0.0002 | 0.0001 | 0.0001 | 0.0001 |
| Bud Neck | 0.012 | 0.0007 | 0.0016 | 0.0018 | 0.0017 | 0.0017 | 0.011 | 0.0004 | 0.0004 | 0.0005 | 0.0005 | 0.0029 | 0.0003 | 0.0003 | 0.0008 | 0.002 | 0.0007 | 0.0011 |
| Bud Periphery | 0.0015 | 0.001 | 0.001 | 0.0004 | 0.0007 | 0.0004 | 0.0004 | 0.0016 | 0.0004 | 0.0001 | 0.0031 | 0.0106 | 0 | 0.0001 | 0.0001 | 0 | 0 | 0 |
| Bud Site | 0.0068 | 0.0122 | 0.0048 | 0.0062 | 0.0014 | 0.0005 | 0.0043 | 0.0111 | 0.0034 | 0.0005 | 0.0033 | 0.0149 | 0.0003 | 0.0031 | 0.0007 | 0.0003 | 0.0002 | 0.0001 |
| Cell Periphery | 0.0005 | 0.0004 | 0.0002 | 0.0002 | 0.0001 | 0.0001 | 0.0004 | 0.0003 | 0.0002 | 0 | 0.0003 | 0.0003 | 0.0001 | 0.0001 | 0.0001 | 0.0001 | 0 | 0 |
| Cytoplasm | 0.1957 | 0.34 | 0.3113 | 0.2184 | 0.2523 | 0.308 | 0.2963 | 0.5742 | 0.4798 | 0.518 | 0.2499 | 0.4236 | 0.3192 | 0.4858 | 0.3875 | 0.5244 | 0.4565 | 0.4701 |
| Cytoplasmic Foci | 0.1981 | 0.1981 | 0.2268 | 0.2193 | 0.209 | 0.2335 | 0.2154 | 0.1309 | 0.1543 | 0.1554 | 0.2114 | 0.2083 | 0.1847 | 0.1603 | 0.1973 | 0.1233 | 0.2082 | 0.1717 |
| Eisosomes | 0.0005 | 0.0001 | 0.0002 | 0.0002 | 0.0001 | 0.0001 | 0.0001 | 0.0001 | 0.0001 | 0.0002 | 0.0001 | 0 | 0 | 0 | 0 | 0 | 0 | 0 |
| Endoplasmic Reticulum | 0.0174 | 0.0131 | 0.013 | 0.0111 | 0.011 | 0.011 | 0.0237 | 0.0135 | 0.024 | 0.0061 | 0.0087 | 0.0169 | 0.0244 | 0.0122 | 0.0181 | 0.0106 | 0.0135 | 0.0183 |
| Endosome | 0.2622 | 0.2166 | 0.2041 | 0.3065 | 0.2567 | 0.2112 | 0.2214 | 0.1411 | 0.2087 | 0.215 | 0.3027 | 0.2358 | 0.3074 | 0.2492 | 0.2562 | 0.227 | 0.2058 | 0.2427 |
| Golgi | 0.0174 | 0.0094 | 0.0106 | 0.0149 | 0.0173 | 0.0104 | 0.0164 | 0.005 | 0.0089 | 0.0088 | 0.025 | 0.0157 | 0.0075 | 0.0069 | 0.0085 | 0.005 | 0.008 | 0.0063 |
| Lipid Particles | 0.0481 | 0.0239 | 0.0157 | 0.0382 | 0.0123 | 0.0237 | 0.0256 | 0.0052 | 0.0102 | 0.0037 | 0.0375 | 0.0122 | 0.0158 | 0.0045 | 0.01 | 0.0116 | 0.0058 | 0.0066 |
| Mitochondria | 0.0122 | 0.0014 | 0.0024 | 0.0025 | 0.0047 | 0.0051 | 0.003 | 0.0005 | 0.0161 | 0.0011 | 0.0515 | 0.0114 | 0.0005 | 0.0007 | 0.001 | 0.0014 | 0.0012 | 0.0011 |
| None | 0.1193 | 0.1246 | 0.1393 | 0.1172 | 0.1435 | 0.1432 | 0.0968 | 0.0811 | 0.0559 | 0.0044 | 0.0105 | 0.0058 | 0.0937 | 0.05 | 0.0791 | 0.0496 | 0.0663 | 0.0375 |
| Nuclear Periphery | 0.0164 | 0.0064 | 0.0091 | 0.0072 | 0.0038 | 0.0082 | 0.0067 | 0.0064 | 0.0088 | 0.0041 | 0.0134 | 0.006 | 0.0129 | 0.006 | 0.0079 | 0.0116 | 0.0099 | 0.0122 |
| Nucleolus | 0.0044 | 0.0024 | 0.0007 | 0.001 | 0.0009 | 0.0021 | 0.0022 | 0.0002 | 0.0004 | 0 | 0.0004 | 0.0002 | 0.0002 | 0.0001 | 0.0006 | 0.0003 | 0.0001 | 0.0001 |
| Nucleus | 0.0158 | 0.012 | 0.0058 | 0.0048 | 0.0031 | 0.0063 | 0.0036 | 0.0035 | 0.0059 | 0.0017 | 0.0025 | 0.0034 | 0.0037 | 0.0038 | 0.0044 | 0.0104 | 0.005 | 0.0062 |
| Peroxisomes | 0.0186 | 0.0097 | 0.0096 | 0.027 | 0.0236 | 0.0128 | 0.0287 | 0.0034 | 0.0031 | 0.0031 | 0.0321 | 0.0079 | 0.004 | 0.0024 | 0.0087 | 0.002 | 0.0048 | 0.0063 |
| Punctate Nuclear | 0.0201 | 0.0151 | 0.012 | 0.0079 | 0.0319 | 0.0098 | 0.0072 | 0.0029 | 0.0042 | 0.0072 | 0.0045 | 0.0044 | 0.0093 | 0.0037 | 0.008 | 0.0069 | 0.0065 | 0.0081 |
| Vacuole | 0.0103 | 0.0088 | 0.0071 | 0.0038 | 0.0044 | 0.0076 | 0.0131 | 0.0068 | 0.0098 | 0.0101 | 0.026 | 0.0042 | 0.0136 | 0.0085 | 0.0085 | 0.01 | 0.0057 | 0.0085 |
| Vacuole Periphery | 0.0023 | 0.0011 | 0.0014 | 0.0013 | 0.0014 | 0.0014 | 0.0015 | 0.0007 | 0.002 | 0.0026 | 0.0112 | 0.0022 | 0.0019 | 0.0013 | 0.0016 | 0.0023 | 0.0013 | 0.0023 |
Sequencing Data
| R1 | R2 | |||||||||
|---|---|---|---|---|---|---|---|---|---|---|
| G1 Post-START | S/G2 | Metaphase | Anaphase | Telophase | G1 Post-START | S/G2 | Metaphase | Anaphase | Telophase | |
| Gene Expression | 28.6479 | 18.1744 | 12.2602 | 27.9792 | 13.7789 | 18.4723 | 33.8288 | 26.4966 | 21.9236 | 24.9094 |
| Translational Efficiency | 0.4919 | 0.6922 | 0.8706 | 0.3393 | 0.5956 | 1.0017 | 0.4656 | 0.5516 | 0.7603 | 0.5913 |
Hit Data
| Dataset | Hit |
|---|---|
| Protein Concentration | ✘ |
| Protein Localization | ✘ |
| Gene Expression | ✘ |
| Translational Efficiency | ✘ |
Endocytosis
| Temp | Actin Patch (Sac6-tdTomato) | Cortical Patch (Sla1-GFP) | Late Endosome (Snf7-GFP) | Vacuole (Vph1-GFP) |
|---|---|---|---|---|
| 37℃ | ||||
| RT |
Cell Cycle Omics
CYCLoPs (Pfk27-GFP)
| Gene / Allele | Actin Patch (Sac6-tdTomato) | Cortical Patch (Sla1-GFP) | Late Endosome (Snf7-GFP) | Vacuole (Sac6-tdTomato) |
|---|
| Gene | Images |
|---|
| Gene | Images |
|---|
Images are not yet available
Images are not yet available